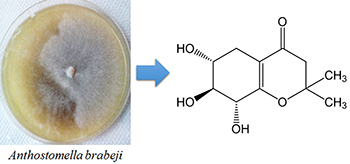

vol. 27, No. 6, 2016, p. 979-1136
Our menu illustrates a recurring struggle that theoretical chemists face in their daily activities regarding their adopted charge model. Should we settle with a free sample that may not be satisfying? Sometimes the affordable choice tastes a little fishy. If you are willing to spend more you might not suffer indigestion! Details are presented in the Review Review of Experimental GAPT and Infrared Atomic Charges in Molecules by Wagner E. Richter, Leonardo J. Duarte, Arnaldo F. Silva and Roy E. Bruns on page 979.
Review of Experimental GAPT and Infrared Atomic Charges in Molecules
Wagner E. Richter; Leonardo J. Duarte; Arnaldo F. Silva; Roy E. Bruns
How to cite this article
Our menu illustrates a recurring struggle that theoretical chemists face in their daily activities regarding their adopted charge model. Should we settle with a free sample that may not be satisfying? Sometimes the affordable choice tastes a little fishy. If you are willing to spend more you might not suffer indigestion! Details are presented in the Review Review of Experimental GAPT and Infrared Atomic Charges in Molecules by Wagner E. Richter, Leonardo J. Duarte, Arnaldo F. Silva and Roy E. Bruns on page 979.
https://dx.doi.org/10.5935/0103-5053.20160105
Review J. Braz. Chem. Soc. 2016, 27(6), 979-991
Review of Experimental GAPT and Infrared Atomic Charges in Molecules
Wagner E. Richter; Leonardo J. Duarte; Arnaldo F. Silva; Roy E. Bruns
How to cite this article

The atomic charges of carbon monoxide from some of the most used charge models. With the exception of generalized atomic polar tensor (GAPT), they all agree well with the almost null dipole moment. We would rather buy quantum theory of atoms in molecules (QTAIM). It's more expensive but works well.
https://dx.doi.org/10.5935/0103-5053.20160105
Articles J. Braz. Chem. Soc. 2016, 27(6), 992-997
Analysis of Blotter Papers Employed in the Commercialization of New Hallucinogenic Substances of the 2,5-Dimethoxy-N-(2-methoxybenzyl) Phenethylamine Series Seized in the City of Bogotá by Applying Gas Chromatography Coupled to a Selective Mass Ion Trap Detector
Diego A. Sánchez Robayo; William F. Garzón Mendez; Gonzalo Taborda Ocampo; Milton Rosero Moreano
How to cite this article

Sample of blotter paper seized in the streets of Bogotá, analyzed by gas chromatography coupled to a selective mass ion trap detector (GC-MS IT) containing three different synthetic drugs.
https://dx.doi.org/10.5935/0103-5053.20150353
J. Braz. Chem. Soc. 2016, 27(6), 998-1006
Oxidative Desulfurization of Gasoline by Ionic Liquids Coupled with Extraction by Organic Solvents
Rashid Abro; Shurong Gao; Xiaochun Chen; Guangren Yu; Ahmed A. Abdeltawab; Salem S. Al-Deyab
How to cite this article

Oxidative desulfurization (ODS) of gasoline by ionic liquids (ILs) coupled with extraction by organic solvents is a potential method to produce clean gasoline.
https://dx.doi.org/10.5935/0103-5053.20150355
J. Braz. Chem. Soc. 2016, 27(6), 1007-1013
Synthesis, Characterization and Catalytic Performance of a Novel Picolinic Acid-12-Molybdophosphoric Acid Hybrid Catalyst
Lijun Liu; Honghong Wang; Shuwen Gong; Jing Lu; Qian Zhang
How to cite this article

A novel picolinic acid-12-molybdophosphoric acid hybrid complex was prepared and characterized. The complex was demonstrated to be a highly efficient and reusable solid-liquid heterogeneous catalyst for esterification.
https://dx.doi.org/10.5935/0103-5053.20150356
J. Braz. Chem. Soc. 2016, 27(6), 1014-1025
Kinetic Analysis of the Decomposition of the KFe3(SO4)2−x(CrO4)x(OH)6 Jarosite Solid Solution in Ca(OH)2 Medium
Ister Mireles; Iván A. Reyes; Víctor H. Flores; Francisco Patiño; Mizraim U. Flores; Martín Reyes; Manuel Acosta; Roel Cruz; Emmanuel J. Gutiérrez
How to cite this article

Jarosite-type compounds can undergo several kinds of substitutions thanks to the different coordination environments in their structure; many of those substitutions can be made by elements of environmental importance, such as chromium(VI). Furthermore, they possess high stability in a wide range of pH and temperature, so they could be excellent deposits of toxic elements.
https://dx.doi.org/10.5935/0103-5053.20150357
J. Braz. Chem. Soc. 2016, 27(6), 1026-1031
Differentiation Among Brazilian Wine Regions Based on Lead Isotopic Data
Cibele M. S. Almeida; Ana C. Almeida; Maria Luíza D. P. Godoy; Tatiana D. Saint'Pierre; José M. Godoy
How to cite this article

Lead isotopic composition was applied as a tool to differentiate among Brazilian red wine origin. The results have demonstrate that is possible to discriminate between wines produced on the Southern region from those produced on Vale do Sao Francisco.
https://dx.doi.org/10.5935/0103-5053.20150358
J. Braz. Chem. Soc. 2016, 27(6), 1032-1039
Antiprotozoal Activity of the Cyclopalladated Complexes Against Leishmania amazonensis and Trypanosoma cruzi
Angela M. A. Velásquez; Rodrigo A. de Souza; Thaís G. Passalacqua; Aline R. Ribeiro; Mateus Scontri; Chung M. Chin; Leticia de Almeida; Mayara L. Del Cistia; Joao A. da Rosa; Antonio E. Mauro; Marcia A. S. Graminha
How to cite this article

The cyclopalladated complexes showed leishmanicidal and trypanocidal activities. [Pd(dmba)(μ-NCO)]2 showed to be the most active compound against Leishmania amazonensis and Trypanosoma cruzi intracellular amastigote forms.
https://dx.doi.org/10.5935/0103-5053.20150360
J. Braz. Chem. Soc. 2016, 27(6), 1040-1047
Biosensor Based on Cysteine Monolayer and Monoclonal Antibody for Specific Detection of Aflatoxin B1 in Rice
Estéfani P. Simao; Gilcelia J. L. S. Barbieri; Cesar A. S. Andrade; Maria D. L. Oliveira
How to cite this article

A self-assembled monolayer of cysteine bound monoclonal antibodies was used to build an immunosensor for aflatoxin B1 detection in rice.
https://dx.doi.org/10.5935/0103-5053.20150361
J. Braz. Chem. Soc. 2016, 27(6), 1048-1054
Compounds of Anthostomella brabeji, an Endophytic Fungus Isolated from Paepalanthus planifolius (Eriocaulaceae)
Marcelo R. de Amorim; Andressa Somensi; Angela R. Araujo; Bruna V. Bonifácio; Tais M. Bauab; Lourdes C. dos Santos
How to cite this article
New compound (+)-(6R*,7S*,8R*)-6,7,8-trihydroxy-2,2-dimethyl-5,6,7,8-tetrahydro-chroman-4-one isolated from Anthostomella brabeji.
https://dx.doi.org/10.5935/0103-5053.20150362
J. Braz. Chem. Soc. 2016, 27(6), 1055-1059
Determination of Phenolic Acids and Quercetin in Brazilian Red Wines from Vale do Sao Francisco Region Using Liquid-Liquid Ultrasound-Assisted Extraction and HPLC-DAD-MS
Fabio de S. Dias; Jorge M. David; Juceni P. David
How to cite this article

Phenolic compounds are responsible for the colors and flavors of wines, and their presence has been associated with some beneficial effects on human health. In this work chromatographic methods were used for the determination of phenolic acids in wines produced from the Sao Francisco region, Brazil, which is in the boundary between Bahia and Pernambuco States.
https://dx.doi.org/10.5935/0103-5053.20150363
J. Braz. Chem. Soc. 2016, 27(6), 1060-1066
Effect of Metal Dispersion on the Hydrogenation of 2-Amyl Anthraquinone over Pd/Al2O3 Catalyst
Xiaotong Li; Hongjiu Su; Gaoyuan Ren; Shudong Wang
How to cite this article

The turnover frequency (TOF) of amyl anthraquinone showed antipathetic size dependence. The space time yield (STY) of hydrogen peroxide peaked at 4 nm.
https://dx.doi.org/10.5935/0103-5053.20160001
J. Braz. Chem. Soc. 2016, 27(6), 1067-1077
Quantification of Synthetic Amino-Nitroquinoxaline Dyes: An Approach Using Image Analysis
Lilian C. da Silva; Djalan F. de Lima; Janine A. Silva; Camilo L. M. de Morais; Brunno L. Albuquerque; Adailton J. Bortoluzzi; Josiel B. Domingos; Renata M. Araújo; Fabrício G. Menezes; Kássio M. G. Lima
How to cite this article

This paper describes the use of digital imaging acquired from a conventional desktop scanner for characterization of newly synthesized amino-nitroquinoxaline dyes through their color change signatures.
https://dx.doi.org/10.5935/0103-5053.20160002
J. Braz. Chem. Soc. 2016, 27(6), 1078-1082
Derivatives of Cardanol through the Ene Reaction with Diethyl Azodicarboxylate
Atanu Biswas; Carlucio R. Alves; Maria T. S. Trevisan; Janet Berfield; Roselayne F. Furtado; Zengshe Liu; Huai N. Cheng
How to cite this article

Schematic reaction of cardanol with diethyl azodicarboxylate to form one of the ene reaction products.
https://dx.doi.org/10.5935/0103-5053.20160003
J. Braz. Chem. Soc. 2016, 27(6), 1083-1093
Improvement of the Extraction Process for High Commercial Value Pigments from Desmodesmus sp. Microalgae
Aline T. Soares; Jair G. Marques Júnior; Rafael G. Lopes; Roberto B. Derner; Nelson R. Antoniosi Filho
How to cite this article

Desmodesmus sp. microalgae cultivation leads to high biomass production. Different pigment extraction methods from the microalgae cells were tested. Chromatographic identification and quantification from pigments extract revealed the major carotenoids in different extraction methods.
https://dx.doi.org/10.5935/0103-5053.20160004
J. Braz. Chem. Soc. 2016, 27(6), 1094-1102
Efficient Mineralization of Paracetamol Using the Nanocomposite TiO2/Zn(II) Phthalocyanine as Photocatalyst
Marcela D. França; Lidiaine M. Santos; Tatiana A. Silva; Karen A. Borges; Valdislaine M. Silva; Antonio O. T. Patrocinio; Alam G. Trovó; Antonio E. H. Machado
How to cite this article

A TiO2/Zn(II) phthalocyanine nanocomposite ( ) showed to be up to 15% better than TiO2-P25 (
) showed to be up to 15% better than TiO2-P25 ( ) in promoting the mineralization of paracetamol. For both photocatalysts the mineralization is affected by pH of the reaction medium with maximum efficiency nearby their isoelectric points.
) in promoting the mineralization of paracetamol. For both photocatalysts the mineralization is affected by pH of the reaction medium with maximum efficiency nearby their isoelectric points.
https://dx.doi.org/10.5935/0103-5053.20160007
J. Braz. Chem. Soc. 2016, 27(6), 1103-1108
Synthesis of CL-20 from TADB in a One-Pot Method by Zeolite/HNO3 as a New Nitrolysis System
Yadollah Bayat; Fatemeh Hajighasemali; Ali Mohajeri
How to cite this article

Hexanitrohexaazaisowurtzitane (CL-20), the most energetic explosive known to date, has been synthesized through a one-pot nitrolysis reaction using zeolite/HNO3.The optimization of reaction parameters has been studied.
https://dx.doi.org/10.5935/0103-5053.20160008
J. Braz. Chem. Soc. 2016, 27(6), 1109-1115
Synthesis of Novel 2-Aryl-3-(2-morpholinoethyl)-1,3-thiazinan-4-ones Via Ultrasound Irradiation
Daniela P. Gouvêa; Gabriele A. Berwaldt; Patrícia D. Neuenfeldt; Ricardo J. Nunes; Wanda P. Almeida; Wilson Cunico
How to cite this article

Thiazinanones from 2-morpholinoethylamine were obtained by thermal heating and sonochemistry methodologies.
https://dx.doi.org/10.5935/0103-5053.20160009
Short Report J. Braz. Chem. Soc. 2016, 27(6), 1116-1120
Enantiomeric Separation of Sibutramine by Capillary Zone Electrophoresis
Gabriel Hancu; Alexandra Hilochie; Alexandru-Robert Vlad; Anca Cârje; Amelia Tero-Vescan
How to cite this article

Chiral separation of sibutramine enantiomers by capillary zone electrohoresis using cyclodextrins as chiral selectors.
https://dx.doi.org/10.5935/0103-5053.20150359
J. Braz. Chem. Soc. 2016, 27(6), 1121-1128
Acetaminophen Prodrug: Microwave-Assisted Synthesis and in vitro Metabolism Evaluation by Mass Spectrometry
Valter E. Murie; Lucas M. M. Marques; Glória E. P. Souza; Anderson R. M. Oliveira; Norberto P. Lopes; Giuliano C. Clososki
How to cite this article

A microwave-assisted reaction allows the isolation of propacetamol hydrochloride in high purity and yield. Mass spectrometry was used to evaluate an active pharmaceutical ingredient (API) microsomal reaction.
https://dx.doi.org/10.5935/0103-5053.20160005
J. Braz. Chem. Soc. 2016, 27(6), 1129-1136
Appel Reaction of Carboxylic Acids with Tribromoisocyanuric Acid/Triphenylphosphine: a Mild and Acid-Free Preparation of Esters and Amides
Haryadylla da Cunha Sindra; Marcio C. S. de Mattos
How to cite this article

A new and easy methodology for esterification and amidation of carboxylic acids promoted by triphenylphosphine and tribromoisocyanuric acid.
https://dx.doi.org/10.5935/0103-5053.20160006
Online version ISSN 1678-4790 Printed version ISSN 0103-5053
Journal of the Brazilian Chemical Society
JBCS Editorial and Publishing Office
University of Campinas - UNICAMP
13083-970 Campinas-SP, Brazil
Free access










